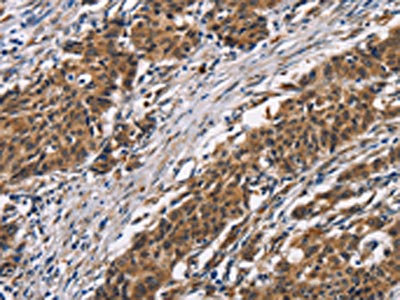

ARSB Antibody
-
中文名稱:ARSB兔多克隆抗體
-
貨號:CSB-PA573955
-
規(guī)格:¥1100
-
圖片:
-
The image on the left is immunohistochemistry of paraffin-embedded Human gastic cancer tissue using CSB-PA573955(ARSB Antibody) at dilution 1/50, on the right is treated with synthetic peptide. (Original magnification: ×200)
-
The image on the left is immunohistochemistry of paraffin-embedded Human thyroid cancer tissue using CSB-PA573955(ARSB Antibody) at dilution 1/50, on the right is treated with synthetic peptide. (Original magnification: ×200)
-
Gel: 6%SDS-PAGE, Lysate: 40 μg, Lane: Human fetal liver tissue, Primary antibody: CSB-PA573955(ARSB Antibody) at dilution 1/340, Secondary antibody: Goat anti rabbit IgG at 1/8000 dilution, Exposure time: 10 minutes
-
-
其他:
產(chǎn)品詳情
-
Uniprot No.:
-
基因名:ARSB
-
別名:Arsb antibody; ARSB_HUMAN antibody; Arylsulfatase B antibody; ArylsulfataseB antibody; ASB antibody; G4S antibody; MPS6 antibody; N acetylgalactosamine 4 sulfatase antibody; N-acetylgalactosamine-4-sulfatase antibody
-
宿主:Rabbit
-
反應(yīng)種屬:Human
-
免疫原:Synthetic peptide of Human ARSB
-
免疫原種屬:Homo sapiens (Human)
-
標記方式:Non-conjugated
-
抗體亞型:IgG
-
純化方式:Antigen affinity purification
-
濃度:It differs from different batches. Please contact us to confirm it.
-
保存緩沖液:-20°C, pH7.4 PBS, 0.05% NaN3, 40% Glycerol
-
產(chǎn)品提供形式:Liquid
-
應(yīng)用范圍:ELISA,WB,IHC
-
推薦稀釋比:
Application Recommended Dilution ELISA 1:1000-1:2000 WB 1:200-1:1000 IHC 1:50-1:200 -
Protocols:
-
儲存條件:Upon receipt, store at -20°C or -80°C. Avoid repeated freeze.
-
貨期:Basically, we can dispatch the products out in 1-3 working days after receiving your orders. Delivery time maybe differs from different purchasing way or location, please kindly consult your local distributors for specific delivery time.
-
用途:For Research Use Only. Not for use in diagnostic or therapeutic procedures.
相關(guān)產(chǎn)品
靶點詳情
-
功能:Removes sulfate groups from chondroitin-4-sulfate (C4S) and regulates its degradation. Involved in the regulation of cell adhesion, cell migration and invasion in colonic epithelium. In the central nervous system, is a regulator of neurite outgrowth and neuronal plasticity, acting through the control of sulfate glycosaminoglycans and neurocan levels.
-
基因功能參考文獻:
- Findings indicate that lower arylsulfatase B (ARSB) is associated with prostate cancer recurrence. PMID: 29081414
- Of the 20 patients included in the study, molecular genetic analysis was performed on 17 patients... molecular analysis results of four patients who was excluded from the overall study (three of which were another adult male siblings who did not receive ERT and one patient whose ERT duration was shorter than 6 months) were were included in determination of allele frequency of ARSB. PMID: 28884960
- Three novel mutations in ARSB were detected, expanding the mutational spectrum of ARSB causing MPS VI. A compound heterozygous for the c.464G>A (p.C155Y) and c.1163G>C (p.R388T) mutations, a 13.8-kb deletion encompassing exons 2 and 3, mutation c.479G>A (p.R160Q), and novel c.464G>A (p.C155Y) mutation. PMID: 27797586
- Mutation analysis of 19 Indian mucopolysaccharidosis VI patients revealed the presence of a total of 15 different mutations of which twelve were novel. PMID: 27826022
- Nine novel mutations of ARSB were identified in MPS VI cases from India in the present study. The study also provides some insights into the genotype-phenotype association in MPS VI PMID: 26609033
- Silencing Wnt9A increased the expression of CHST11 in the colonic epithelial cells, and chromatin immunoprecipitation assay demonstrated enhancing effects of Wnt9A siRNA and exogenous BMP4 on the CHST11 promoter PMID: 25511584
- Arylsulfatase B regulates versican expression by galectin-3 and AP-1 mediated transcriptional effects. PMID: 24240681
- Mutation analysis of the ARSB gene revealed seven missense and three frameshift mutations of which eight were novel. PMID: 24677745
- These studies reveal how carrageenan exposure can lead to transcriptional events in colonic epithelial cells through decline in arylsulfatase B activity, with subsequent impact on C4S, galectin-3, Sp1, and Wnt9A PMID: 24778176
- novel homozygous missense mutation, c.278 C>T, p.P93L, associated with mucopolysaccharidosis type VI PMID: 23855929
- ARSB activity was significantly higher in the normal tissues. PMID: 23835622
- PTC124 but not gentamicin, increases the level of ARSB activity. PMID: 22971959
- results indicate that mammalian ARSB improves functional recovery after CNS injury. PMID: 23520469
- Arylsulfatase B activity was significantly less in the polymorphonuclear leukocytes and mononuclear cells from the cystic fibrosis patients than controls. PMID: 22550062
- Sequencing analysis revealed a novel homozygous missense mutation in the ARSB gene at c.1457A PMID: 23023219
- investigation of substrate specificity of arylsulfatase B in colonic epithelial cells; competitive binding of complex polysaccharides/glycosaminoglycans with arylsulfatase B can affect generation of reactive oxygen species and inflammatory response PMID: 22079206
- Hypoxia reduces arylsulfatase B activity and silencing arylsulfatase B replicates and mediates the effects of hypoxia. PMID: 22428001
- 13 mucopolysaccharidosis type VI patients were found to be homozygous for the previously undescribed H178L ARSB mutation PMID: 21996138
- Altered ARSB immunostaining and reduced activity may be useful indicators of malignant transformation in human colonic tissue. PMID: 21378286
- Mucopolysaccharidosis type VI: Structural and clinical implications of mutations in N-acetylgalactosamine-4-sulfatase PMID: 11668612
- Seven novel mutation were identified in ARSB in mucopolysaccharidosis type VI patients undergoing a Clinical trial of enzyme replacement therapy, 3 of these mutations resulted in truncated proteins. PMID: 14974081
- analysis of novel mutations on the arylsulphatase B gene in South American Mucopolysaccharidosis type VI patients PMID: 16435196
- Decreased arylsulfatase B activity is associated with cystic fibrosis PMID: 17324393
- The identification of many novel mutations unique to individuals/their families highlighted the genetic heterogeneity of the mucopolysaccharidosis VI disorder. PMID: 17458871
- Novel mutations in arylsulfatase B is associated with mucopolysaccharidosis VI PMID: 17643332
- modification of expression of the lysosomal sulfatases ASB and GALNS regulates the content of CSs. PMID: 18285341
- Reduced activity of arylsulfatase B enzymatic activity in children with cystic fibrosis PMID: 18299243
- All the ARSB mutations studied had a significant effect on enzyme activity, protein processing and/or mRNA stability. PMID: 18406185
- arylsulfatase B gene mutation profile in Taiwanese MPS VI patients may be different from MPS VI patients from other countries[mucopolysaccharidosis type VI ] PMID: 18486607
- IL-8 increases in bronchial epithelial cells after arylsulfatase B silencing due to sequestration with chondroitin-4-sulfate PMID: 19346317
顯示更多
收起更多
-
相關(guān)疾病:Mucopolysaccharidosis 6 (MPS6); Multiple sulfatase deficiency (MSD)
-
亞細胞定位:Lysosome. Cell surface.
-
蛋白家族:Sulfatase family
-
數(shù)據(jù)庫鏈接:
Most popular with customers
-
YWHAB Recombinant Monoclonal Antibody
Applications: ELISA, WB, IHC, IF, FC
Species Reactivity: Human, Mouse, Rat
-
-
-
-
-
-
-